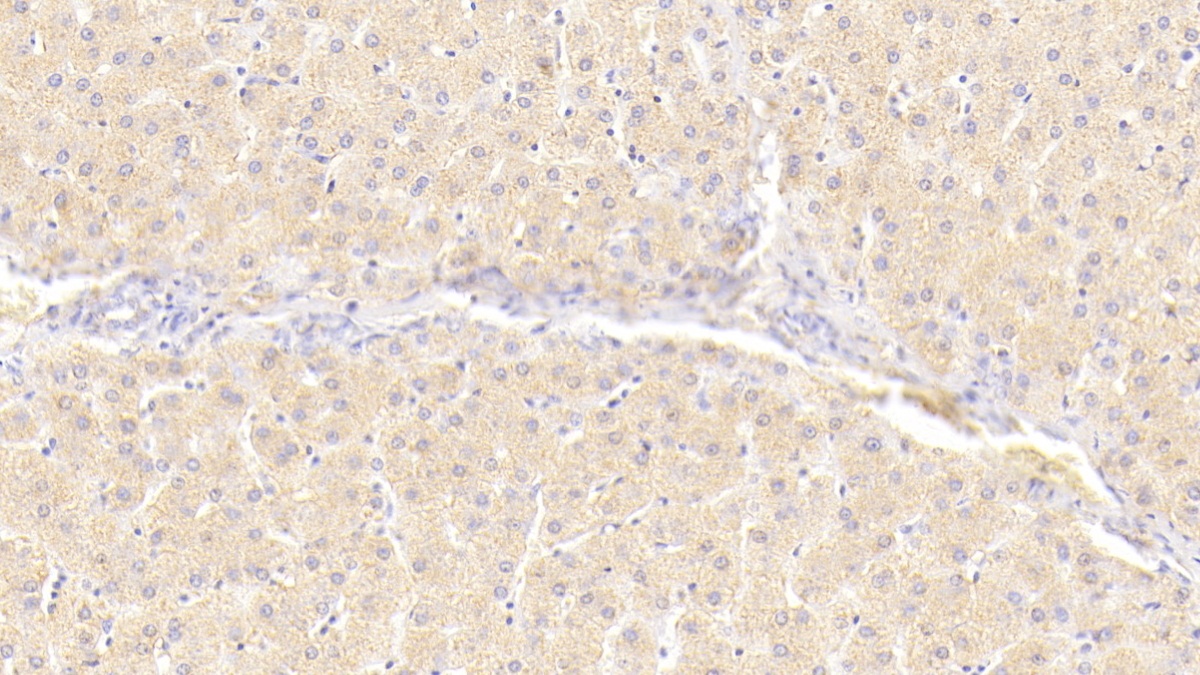

Polyclonal Antibody to Insulin Receptor (INSR)
CD220; ISR; HHF5; IR
- Product No.PAA895Hu03
- Organism SpeciesHomo sapiens (Human) Same name, Different species.
- SourcePolyclonal antibody preparation
- HostRabbit
- Potencyn/a
- Ig Type IgG
- PurificationAntigen-specific affinity chromatography followed by Protein A affinity chromatography
- LabelNone
- Immunogen RPA895Hu03-Recombinant Insulin Receptor (INSR)
- Buffer FormulationPBS, pH7.4, containing 0.02% NaN3, 50% glycerol.
- TraitsLiquid
- Concentration500µg/mL
- Organism Species Moren/a
- ApplicationsWB; IHC; ICC/IF
If the antibody is used in flow cytometry, please check FCM antibodies. - DownloadInstruction Manual
- UOM 20µl100µl 200µl 1ml 10ml
- FOB
US$ 95
US$ 221
US$ 316
US$ 790
US$ 3160
For more details, please contact local distributors!
SPECIFITY
The antibody is a rabbit polyclonal antibody raised against INSR. It has been selected for its ability to recognize INSR in immunohistochemical staining and western blotting.
USAGE
Western blotting: 0.5-2µg/mL;
Immunohistochemistry: 5-20µg/mL;
Immunocytochemistry: 5-20µg/mL;
Optimal working dilutions must be determined by end user.
STORAGE
Store at 4°C for frequent use. Stored at -20°C in a manual defrost freezer for two year without detectable loss of activity. Avoid repeated freeze-thaw cycles.
STABILITY
The thermal stability is described by the loss rate. The loss rate was determined by accelerated thermal degradation test, that is, incubate the protein at 37°C for 48h, and no obvious degradation and precipitation were observed. The loss rate is less than 5% within the expiration date under appropriate storage condition.
GIVEAWAYS
INCREMENT SERVICES
-
 Antibody Labeling Customized Service
Antibody Labeling Customized Service
-
 Protein A/G Purification Column
Protein A/G Purification Column
-
 Staining Solution for Cells and Tissue
Staining Solution for Cells and Tissue
-
 Positive Control for Antibody
Positive Control for Antibody
-
 Tissue/Sections Customized Service
Tissue/Sections Customized Service
-
 Phosphorylated Antibody Customized Service
Phosphorylated Antibody Customized Service
-
 Western Blot (WB) Experiment Service
Western Blot (WB) Experiment Service
-
 Immunohistochemistry (IHC) Experiment Service
Immunohistochemistry (IHC) Experiment Service
-
 Immunocytochemistry (ICC) Experiment Service
Immunocytochemistry (ICC) Experiment Service
-
 Flow Cytometry (FCM) Experiment Service
Flow Cytometry (FCM) Experiment Service
-
 Immunoprecipitation (IP) Experiment Service
Immunoprecipitation (IP) Experiment Service
-
 Immunofluorescence (IF) Experiment Service
Immunofluorescence (IF) Experiment Service
-
 Buffer
Buffer
-
 DAB Chromogen Kit
DAB Chromogen Kit
-
 SABC Kit
SABC Kit
-
 Long-arm Biotin Labeling Kit
Long-arm Biotin Labeling Kit
-
 Real Time PCR Experimental Service
Real Time PCR Experimental Service
| Magazine | Citations |
| IOSR Journal of Applied Chemistry | Molecular and Biochemical Effect of Neem Extract On Experimental Diabetes Org:Source |
| Biol Pharm Bull | Age-Dependent Onset of Insulin Resistance in Insulin-Resistant Mice PubMed: 26632184 |
| Nanomedicine | A newly developed silymarin nanoformulation as a potential antidiabetic agent in experimental diabetes pubmed:27623396 |
| American Journal of Translational Research | Subcutaneous liraglutide ameliorates methylglyoxal-induced Alzheimer-like tau pathology and cognitive impairment by modulating tau hyperphosphorylation and glycogen synthase kinase-3β. pubmed:28337257 |
| Biomedicine & Pharmacotherapy | Vitamin D3 intake as regulator of insulin degrading enzyme and insulin receptor phosphorylationin diabetic rats. pubmed:27930980 |
| Eur Neuropsychopharmacol. | Regulation of insulin receptor phosphorylation in the brains of prenatally stressed rats: New insight into the benefits of antidepressant drug treatment. pubmed:28063625 |
| 台湾农业研究 | (台灣農業研究67 (4): 355-364) 香菇柄水萃物改善糖尿病降低阿茲海默氏症罹病風險初探 |
| Scientific Reports | Mechanism underlying starvation-dependent modulation of olfactory behavior in Drosophila larva Pubmed: 32080342 |
| ADVANCED RESEARCHES | Prenatal Stress Induced Spatial Memory Deficit in a Sex-Specific Manner in Mice: Possible Involvement of Hippocampal Insulin Resistance |
| Current Biology | Internal State Affects Local Neuron Function in an Early Sensory Processing Center to Shape Olfactory Behavior in Drosophila Larvae |